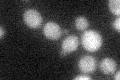
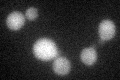
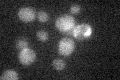

View description
Phosphatidylinositol 4,5-bisphosphate 5-phosphatase, synaptojanin-like protein with an N-terminal Sac1 domain, plays a role in phosphatidylinositol 4,5-bisphosphate homeostasis and in endocytosis; null mutation confers cold-tolerant growth
Localization:
Intensity:
Fold change:
Significance:
-
C’ GFP library in SD
cytosol22.22 -
N' NOP1pr-GFP in SD

punctate,mitochondria70.3343 -
N' TEF2pr-mCherry in SD

missing0 -
N' NATIVEpr-GFP in SD

below threshold15.7774 -
N' TEF2pr-VC and Cyto-VN in SD

#N/A0 -
C’ GFP library in SD+DTT
cytosol23.251.04No -
C’ GFP library in SD+H2O2

cytosol21.840.98No -
C’ GFP library in Starvation Media
cytosol22.511.01No -
C’ GFP library on the background of Pup2-DaMP

cytosol -
C’ GFP library on the background of CCT mutant

cytosol23.77271.06912No
